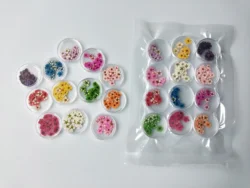
Hot selling wholesale custom trendy high quality flowers pattern nail stickers decal

Hot selling wholesale custom trendy high quality flowers pattern nail stickers decal
- Category: >>>
- Supplier: Yangjiang Jiangcheng Xugao Industry And Trade Co. Ltd.
Share on (62581279656):
Product Overview
Description
Product Description
item | value |
Place of Origin | China |
Province | Guangdong |
Brand Name | XuGao |
Model Number | XG 354 |
Material | Plastic |
Type | 3D |
Product name | Nail Decoration |
Design | Customed Designs |
Color | Customers' Requirements |
Package | Opp Bag |
MOQ | 10 Bags |
Delivery Time | 7-15days |
OEM | Accepatble |






Q:Are you a factory or trading company?
A: Original factory with OEM/ODM service.
Q:Where is your factory?
A:Yangjiang City, Guangdong province, China.
Q: How can i get the samples?
A: We will send you free samples but only charge for the freight.
Q:How can i make a order and payment?
A: Please contact our sales, they will offer you professional service. We accept TT, Western union, paypal and so on.
Q: How to receive a sample from us?
A: We are pleased to offer samples if you find the styles you are interested in or send us your own designs. Sample cost can be discussed according to different value of samples.
Q:How about the after-sale service?
A:Please contact your sale server by email, any question will be responsed within 24hours.
Q:How many products do you do in one month?
We can do more than 300000pieces a month for common products, other diffcult process products we can do more than 50000 pieces a month
A: Original factory with OEM/ODM service.
Q:Where is your factory?
A:Yangjiang City, Guangdong province, China.
Q: How can i get the samples?
A: We will send you free samples but only charge for the freight.
Q:How can i make a order and payment?
A: Please contact our sales, they will offer you professional service. We accept TT, Western union, paypal and so on.
Q: How to receive a sample from us?
A: We are pleased to offer samples if you find the styles you are interested in or send us your own designs. Sample cost can be discussed according to different value of samples.
Q:How about the after-sale service?
A:Please contact your sale server by email, any question will be responsed within 24hours.
Q:How many products do you do in one month?
We can do more than 300000pieces a month for common products, other diffcult process products we can do more than 50000 pieces a month

We Recommend
New Arrivals
New products from manufacturers at wholesale prices